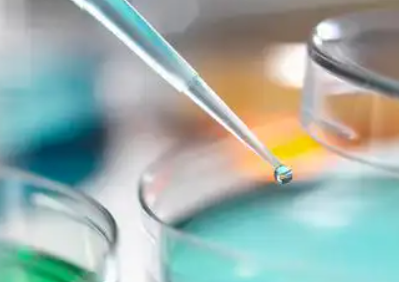
image.png

青島醫(yī)院捐獻(xiàn)干細(xì)胞有哪些,捐獻(xiàn)流程是怎樣的
2024-11-14 16:12:53 來源: 小編 咨詢醫(yī)生
干細(xì)胞捐獻(xiàn)是一項(xiàng)拯救生命的重要事業(yè),青島作為一座現(xiàn)代化城市,擁有完善的醫(yī)療機(jī)構(gòu)和捐獻(xiàn)體系。本文將詳細(xì)介紹青島醫(yī)院捐獻(xiàn)干細(xì)胞的相關(guān)類型以及捐獻(xiàn)流程,以幫助有意愿參與捐獻(xiàn)的朋友更好地了解這一過程。
一、青島醫(yī)院捐獻(xiàn)干細(xì)胞的類型
1.造血干細(xì)胞:造血干細(xì)胞是體內(nèi)能夠分化為各種血細(xì)胞的細(xì)胞,主要用于治療血液病、免疫性疾病等。捐獻(xiàn)造血干細(xì)胞主要采取外周血干細(xì)胞采集的方式。
2.間充質(zhì)干細(xì)胞:間充質(zhì)干細(xì)胞是一種具有多能分化潛能的干細(xì)胞,可以分化為骨骼、軟骨、脂肪、肌肉等多種細(xì)胞類型。間充質(zhì)干細(xì)胞主要用于治療骨折、軟骨損傷、神經(jīng)系統(tǒng)疾病等。
3.臍帶血干細(xì)胞:臍帶血干細(xì)胞是指新生兒臍帶血中富含的干細(xì)胞,具有較高的分化潛能,可以用于治療多種疾病。
二、青島醫(yī)院捐獻(xiàn)干細(xì)胞的流程
1.捐獻(xiàn)前咨詢:捐**需到青島指定的醫(yī)療機(jī)構(gòu)進(jìn)行咨詢,了解干細(xì)胞捐獻(xiàn)的相關(guān)知識,包括捐獻(xiàn)類型、捐獻(xiàn)過程、捐獻(xiàn)對身體的影響等。
2.捐**篩選:在咨詢后,捐**需進(jìn)行相關(guān)檢查,包括血型、染色體、感染性疾病等,確保捐**身體健康,適合進(jìn)行干細(xì)胞捐獻(xiàn)。
3.捐**登記:通過篩選的捐**需在醫(yī)療機(jī)構(gòu)進(jìn)行登記,成為干細(xì)胞捐獻(xiàn)志愿者。
4.干細(xì)胞采集:根據(jù)捐獻(xiàn)類型,捐**需進(jìn)行相應(yīng)的干細(xì)胞采集。造血干細(xì)胞采集通常采用外周血干細(xì)胞采集,間充質(zhì)干細(xì)胞采集則需進(jìn)行脂肪組織或骨髓穿刺。
5.干細(xì)胞制備與保存:采集到的干細(xì)胞需在專業(yè)實(shí)驗(yàn)室進(jìn)行制備,去除雜質(zhì)、培養(yǎng)擴(kuò)增,最后將制備好的干細(xì)胞保存于低溫冰箱。
6.捐**跟蹤與關(guān)懷:干細(xì)胞捐獻(xiàn)后,醫(yī)療機(jī)構(gòu)會對捐**進(jìn)行跟蹤與關(guān)懷,了解捐**的身體恢復(fù)情況,確保捐**的健康。
7.干細(xì)胞移植:捐獻(xiàn)的干細(xì)胞將用于救治患者,移植過程需在專業(yè)醫(yī)生指導(dǎo)下進(jìn)行,確保移植成功。
三、總結(jié)
青島醫(yī)院捐獻(xiàn)干細(xì)胞事業(yè)得到了廣泛關(guān)注和支持,捐獻(xiàn)流程嚴(yán)謹(jǐn)、規(guī)范。通過參與干細(xì)胞捐獻(xiàn),我們不僅可以幫助他人重獲健康,還能為我國的醫(yī)學(xué)事業(yè)做出貢獻(xiàn)。有意愿的朋友可以前往青島指定的醫(yī)療機(jī)構(gòu)進(jìn)行咨詢,了解捐獻(xiàn)流程,為拯救生命貢獻(xiàn)自己的力量。
- 2024-10-25漢氏聯(lián)合干細(xì)胞公司怎么樣?有哪些干細(xì)胞服務(wù)?
- 2024-10-12干細(xì)胞技術(shù)治療椎間盤突出效果如何?哪些醫(yī)院提供此類治療?
- 2024-12-07中國干細(xì)胞合法機(jī)構(gòu)有幾家,國內(nèi)知名企業(yè)一覽
- 2024-07-23南京軍區(qū)總醫(yī)院干細(xì)胞,南京軍區(qū)總醫(yī)院干細(xì)胞移植怎么樣
- 2024-10-21云南常見干細(xì)胞檢測機(jī)構(gòu)推薦:哪家更權(quán)威?
- 2024-10-14干細(xì)胞哪家最權(quán)威
- 2024-10-11海藍(lán)之謎海藻干細(xì)胞功效有哪些?值得購買嗎?
- 2024-08-10干細(xì)胞治療中風(fēng),干細(xì)胞治療中風(fēng)新進(jìn)展
- 2024-10-11打一針干細(xì)胞要多少錢?影響因素有哪些?
- 2024-09-12蘋果干細(xì)胞有副作用嗎,附功效和注意事項(xiàng)
- 2024-08-22為什么要存儲臍帶干細(xì)胞,詳解其儲存必要性
- 2024-09-04干細(xì)胞抗衰老有效果嗎,有副作用嗎
- 2024-07-23武漢哪個(gè)醫(yī)院做干細(xì)胞,武漢做干細(xì)胞的醫(yī)院哪家好
- 2024-08-02什么是造血干細(xì)胞,造血干細(xì)胞移植需要多少錢
- 2024-08-29干細(xì)胞存儲完整流程與注意事項(xiàng)
- 2024-08-05美國干細(xì)胞技術(shù),美國干細(xì)胞技術(shù)怎么樣
- 2024-08-26捐獻(xiàn)干細(xì)胞過程難受嗎,對身體有影響嗎
- 2024-09-04南京軍區(qū)總醫(yī)院干細(xì)胞治療腎病怎么樣
